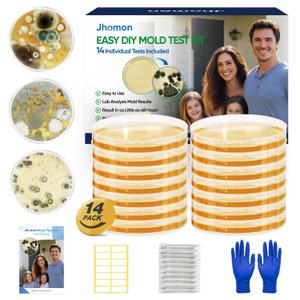
Mold Test Kit for Home, 14 Simple Mold Detectors with Detailed Mold Identification Guide, DIY Mold Testing Kit for Home Surfaces & Indoor Air Quality & HVAC & Car, Results in 48 Hours, 14PCS

Mold Test Kit for Home,7 Simple Detection Tests,Test HVAC System,Home Surfaces, Indoor Air Quality Testing,DIY Mold Detector for Home,Includes Detailed Mold Identification Guide,Black Mold Testing kit
Condition: Appears New
Pickup Details
| Wednesday, Mar 11 | 11:00AM - 06:30PM (Appointment only) |
| Thursday, Mar 12 | 08:00AM - 02:00PM |
| Friday, Mar 13 | 09:00AM - 02:00PM (Appointment only) |
| Saturday, Mar 14 | 08:30AM - 02:00PM |
Product Details
| SKU | OLARR6888564 |
| ASIN | B0DQG6SLF5 |